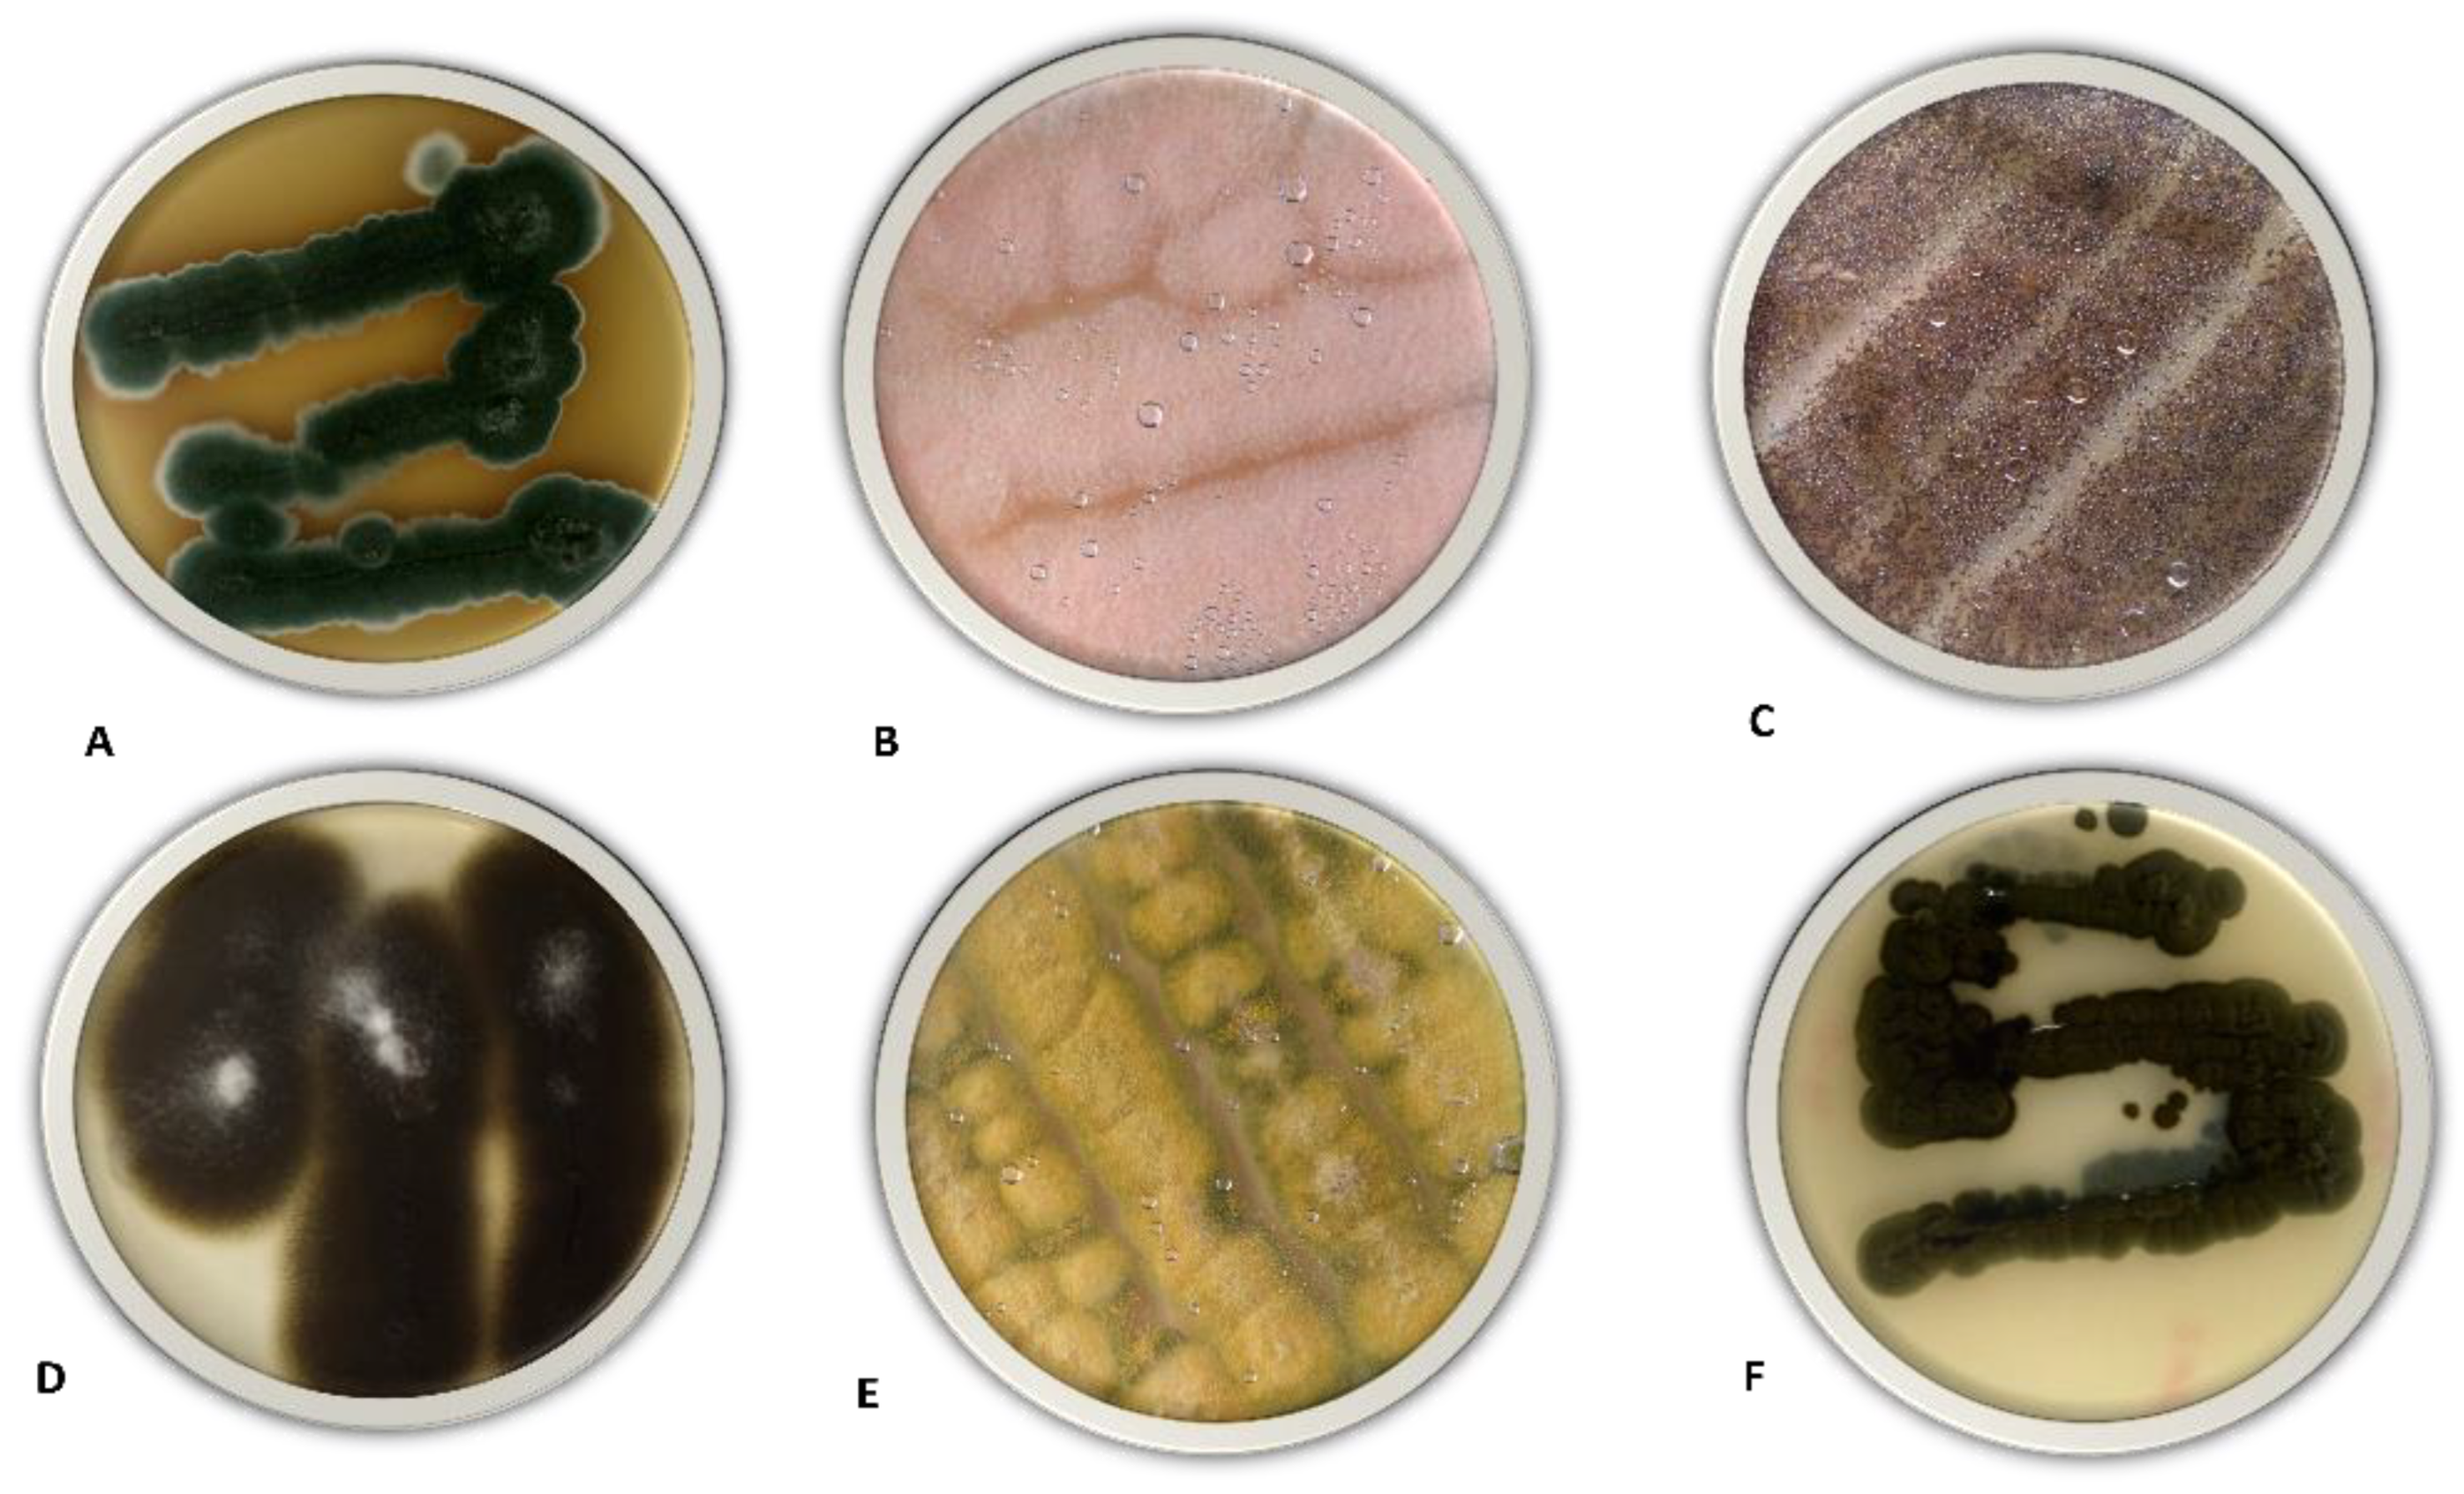
Agriculture 13 00215 g003

Screening and Identification of the Rhizosphere Fungal Communities Associated with Land Reclamation in Egypt
Abstract
1. Introduction
2. Materials and Methods
2.1. Sampling Locations
2.2. Soil Physio-Chemical Characterization
2.3. Fungal Isolation
2.4. DNA Extraction, PCR Amplification, and Sequencing
2.5. Sequence Alignment and Data Analysis
2.6. Phosphate-Solubilizing Test
2.7. Indole Acetic Acid (IAA) Production
3. Results
3.1. Fungal Screening and Isolation
3.2. Species Abundance
3.3. Soil Physio-Chemical Characterization
3.4. Molecular Characterization and Phylogeny
3.5. Phosphate-Solubilizing Test
3.6. Indole Acetic Acid (IAA) Production
4. Discussion
5. Conclusions
Supplementary Materials
Author Contributions
Funding
Institutional Review Board Statement
Data Availability Statement
Acknowledgments
Conflicts of Interest
References
- Jeger, M.; Beresford, R.; Bock, C.; Brown, N.; Fox, A.; Newton, A.; Vicent, A.; Xu, X.; Yuen, J. Global Challenges Facing Plant Pathology: Multidisciplinary Approaches to Meet the Food Security and Environmental Challenges in the Mid-Twenty-First Century. CABI Agric. Biosci. 2021, 2, 20. [Google Scholar] [CrossRef]
- Nadarajah, K.; Abdul Rahman, N.S.N. Plant–Microbe Interaction: Aboveground to Belowground, from the Good to the Bad. IJMS 2021, 22, 10388. [Google Scholar] [CrossRef] [PubMed]
- Rashid, M.I.; Mujawar, L.H.; Shahzad, T.; Almeelbi, T.; Ismail, I.M.I.; Oves, M. Bacteria and Fungi Can Contribute to Nutrients Bioavailability and Aggregate Formation in Degraded Soils. Microbiol. Res. 2016, 183, 26–41. [Google Scholar] [CrossRef]
- Larney, F.J.; Angers, D.A. The Role of Organic Amendments in Soil Reclamation: A Review. Can. J. Soil. Sci. 2012, 92, 19–38. [Google Scholar] [CrossRef]
- Yang, H.-X.; Guo, S.-X.; Liu, R.-J. Characteristics of Arbuscular Mycorrhizal Fungal Diversity and Functions in Saline-Alkali Land. Yingyong Shengtai Xuebao 2015, 26, 311–320. [Google Scholar]
- Vannette, R.L.; Rasmann, S. Arbuscular Mycorrhizal Fungi Mediate Below-Ground Plant-Herbivore Interactions: A Phylogenetic Study. Funct. Ecol. 2012, 26, 1033–1042. [Google Scholar] [CrossRef]
- Hou, M.P.; Oluranti, B.O. Evaluation of Plant Growth Promoting Potential of Four Rhizobacterial Species for Indigenous System. J. Cent. South Univ. 2013, 20, 164–171. [Google Scholar] [CrossRef]
- Igiehon, N.O.; Babalola, O.O. Biofertilizers and Sustainable Agriculture: Exploring Arbuscular Mycorrhizal Fungi. Appl. Microbiol. Biotechnol. 2017, 101, 4871–4881. [Google Scholar] [CrossRef]
- Dias, A.C.F.; Hoogwout, E.F.; Pereira e Silva, M.d.C.; Salles, J.F.; van Overbeek, L.S.; van Elsas, J.D. Potato Cultivar Type Affects the Structure of Ammonia Oxidizer Communities in Field Soil under Potato beyond the Rhizosphere. Soil Biol. Biochem. 2012, 50, 85–95. [Google Scholar] [CrossRef]
- Philippot, L.; Raaijmakers, J.M.; Lemanceau, P.; van der Putten, W.H. Going Back to the Roots: The Microbial Ecology of the Rhizosphere. Nat. Rev. Microbiol. 2013, 11, 789–799. [Google Scholar] [CrossRef]
- Chen, Y.-L.; Xu, T.-L.; Veresoglou, S.D.; Hu, H.-W.; Hao, Z.-P.; Hu, Y.-J.; Liu, L.; Deng, Y.; Rillig, M.C.; Chen, B.-D. Plant Diversity Represents the Prevalent Determinant of Soil Fungal Community Structure across Temperate Grasslands in Northern China. Soil Biol. Biochem. 2017, 110, 12–21. [Google Scholar] [CrossRef]
- Lenc, L.; Kwaśna, H.; Sadowski, C.; Grabowski, A. Microbiota in Wheat Roots, Rhizosphere and Soil in Crops Grown in Organic and Other Production Systems. J. Phytopathol. 2015, 163, 245–263. [Google Scholar] [CrossRef]
- Alexopoulos, C.J.; Mims, C.W.; Blackwell, M. Introductory Mycology; John Wiley and Sons: Hoboken, NJ, USA, 1996; ISBN 0-471-52229-5. [Google Scholar]
- Ainsworth, G.C. Ainsworth & Bisby’s Dictionary of the Fungi; CABI: Wallingford, UK, 2008; ISBN 0-85199-826-7. [Google Scholar]
- Cookson, W.R.; Murphy, D.V.; Roper, M.M. Characterizing the Relationships between Soil Organic Matter Components and Microbial Function and Composition along a Tillage Disturbance Gradient. Soil Biol. Biochem. 2008, 40, 763–777. [Google Scholar] [CrossRef]
- Huang, Y.; Long, X.-E. Contribution of Fungi to Soil Nitrous Oxide Emission and Their Research Methods: A Review. Yingyong Shengtai Xuebao 2014, 25, 1213–1220. [Google Scholar] [PubMed]
- Haas, H. Fungal Siderophore Metabolism with a Focus on Aspergillus fumigatus. Nat. Prod. Rep. 2014, 31, 1266–1276. [Google Scholar] [CrossRef] [PubMed]
- Li, Z.; Bai, T.; Dai, L.; Wang, F.; Tao, J.; Meng, S.; Hu, Y.; Wang, S.; Hu, S. A Study of Organic Acid Production in Contrasts between Two Phosphate Solubilizing Fungi: Penicillium oxalicum and Aspergillus niger. Sci. Rep. 2016, 6, 25313. [Google Scholar] [CrossRef]
- Narsian, V.; Patel, H.H. Aspergillus Aculeatus as a Rock Phosphate Solubilizer. Soil Biol. Biochem. 2000, 32, 559–565. [Google Scholar] [CrossRef]
- Kumar, N.V.; Rajam, K.S.; Rani, M.E. Plant Growth Promotion Efficacy of Indole Acetic Acid (IAA) Produced by a Mangrove Associated Fungi-Trichoderma Viride VKF3. Int. J. Curr. Microbiol. Appl. Sci. 2017, 6, 2692–2701. [Google Scholar] [CrossRef]
- Korkar, M.H.; Magdy, M.; Rizk, S.M.; Fiteha, Y.G.; Atta, A.H.; Rashed, M.A.-S. Rhizosphere-Associated Microbiome Profile of Agriculture Reclaimed Lands in Egypt. Life Sci. 2022. preprint. [Google Scholar]
- Wang, Q.; Ren, Y.; Meng, L.; Li, H.; Fu, H.; Wang, H. Simultaneous Determination of Total Nitrogen and Organic Carbon in Soil with an Elemental Analyzer. Chin. J. Anal. Lab. 2013, 32, 41–45. [Google Scholar]
- Xu, W.; Yuan, W. Responses of Microbial Biomass Carbon and Nitrogen to Experimental Warming: A Meta-Analysis. Soil Biol. Biochem. 2017, 115, 265–274. [Google Scholar] [CrossRef]
- Muhammad, N.; Dai, Z.; Xiao, K.; Meng, J.; Brookes, P.C.; Liu, X.; Wang, H.; Wu, J.; Xu, J. Changes in Microbial Community Structure Due to Biochars Generated from Different Feedstocks and Their Relationships with Soil Chemical Properties. Geoderma 2014, 226–227, 270–278. [Google Scholar] [CrossRef]
- Jones, D.; Willett, V. Experimental Evaluation of Methods to Quantify Dissolved Organic Nitrogen (DON) and Dissolved Organic Carbon (DOC) in Soil. Soil Biol. Biochem. 2006, 38, 991–999. [Google Scholar] [CrossRef]
- Reddy, P.L.N.; Babu, B.S.; Radhaiah, A.; Sreeramulu, A. Screening, Identification and Isolation of Cellulolytic Fungi from Soils of Chittoor District, India. Int. J. Curr. Microbiol. Appl. Sci. 2014, 3, 761–771. [Google Scholar]
- Gaddeyya, G.; Niharika, P.S.; Bharathi, P.; Kumar, P.R. Isolation and Identification of Soil Mycoflora in Different Crop Fields at Salur Mandal. Adv. Appl. Sci. Res. 2012, 3, 2020–2026. [Google Scholar]
- Li, X.; Li, D.; Yan, J.; Zhang, Y.; Wang, H.; Zhang, J.; Ahmed, T.; Li, B. Effect of Plant-Growth-Promoting Fungi on Eggplant (Solanum melongena L.) in New Reclamation Land. Agriculture 2021, 11, 1036. [Google Scholar] [CrossRef]
- White, T.J.; Bruns, T.; Lee, S.; Taylor, J. Amplification and Direct Sequencing of Fungal Ribosomal RNA Genes for Phylogenetics. In PCR Protocols; Elsevier: Amsterdam, The Netherlands, 1990; pp. 315–322. ISBN 978-0-12-372180-8. [Google Scholar]
- Kearse, M.; Moir, R.; Wilson, A.; Stones-Havas, S.; Cheung, M.; Sturrock, S.; Buxton, S.; Cooper, A.; Markowitz, S.; Duran, C.; et al. Geneious Basic: An Integrated and Extendable Desktop Software Platform for the Organization and Analysis of Sequence Data. Bioinformatics 2012, 28, 1647–1649. [Google Scholar] [CrossRef]
- Katoh, K.; Standley, D.M. MAFFT Multiple Sequence Alignment Software Version 7: Improvements in Performance and Usability. Mol. Biol. Evol. 2013, 30, 772–780. [Google Scholar] [CrossRef]
- Price, M.N.; Dehal, P.S.; Arkin, A.P. FastTree 2—Approximately Maximum-Likelihood Trees for Large Alignments. PLoS ONE 2010, 5, e9490. [Google Scholar] [CrossRef]
- Ronquist, F.; Teslenko, M.; van der Mark, P.; Ayres, D.L.; Darling, A.; Höhna, S.; Larget, B.; Liu, L.; Suchard, M.A.; Huelsenbeck, J.P. MrBayes 3.2: Efficient Bayesian Phylogenetic Inference and Model Choice Across a Large Model Space. Syst. Biol. 2012, 61, 539–542. [Google Scholar] [CrossRef]
- Wakelin, S.A.; Gupta, V.V.S.R.; Harvey, P.R.; Ryder, M.H. The Effect of Penicillium Fungi on Plant Growth and Phosphorus Mobilization in Neutral to Alkaline Soils from Southern Australia. Can. J. Microbiol. 2007, 53, 106–115. [Google Scholar] [CrossRef] [PubMed]
- Bano, N.; Musarrat, J. Characterization of a New Pseudomonas Aeruginosa Strain NJ-15 as a Potential Biocontrol Agent. Curr. Microbiol. 2003, 46, 324–328. [Google Scholar] [CrossRef] [PubMed]
- Khamna, S.; Yokota, A.; Lumyong, S. Actinomycetes Isolated from Medicinal Plant Rhizosphere Soils: Diversity and Screening of Antifungal Compounds, Indole-3-Acetic Acid and Siderophore Production. World J. Microbiol. Biotechnol. 2009, 25, 649–655. [Google Scholar] [CrossRef]
- Kacaniova, M.; Fikselová, M. Mycological Flora on Tree Fruits, Crust, Leaves and Pollen Sorbus domestica L. Ann. Agric. Environ. Med. 2007, 14, 229–232. [Google Scholar] [PubMed]
- Anderson, I.C.; Parkin, P.I. Detection of Active Soil Fungi by RT-PCR Amplification of Precursor RRNA Molecules. J. Microbiol. Methods 2007, 68, 248–253. [Google Scholar] [CrossRef] [PubMed]
- Houbraken, J.; Kocsubé, S.; Visagie, C.M.; Yilmaz, N.; Wang, X.-C.; Meijer, M.; Kraak, B.; Hubka, V.; Bensch, K.; Samson, R.A.; et al. Classification of Aspergillus, Penicillium, Talaromyces and Related Genera (Eurotiales): An Overview of Families, Genera, Subgenera, Sections, Series and Species. Stud. Mycol. 2020, 95, 5–169. [Google Scholar] [CrossRef]
- Plassart, P.; Akpa Vinceslas, M.; Gangneux, C.; Mercier, A.; Barray, S.; Laval, K. Molecular and Functional Responses of Soil Microbial Communities under Grassland Restoration. Agric. Ecosyst. Environ. 2008, 127, 286–293. [Google Scholar] [CrossRef]
- Harman, G.E.; Lorito, M.; Lynch, J.M. Uses of Trichoderma Spp. to Alleviate or Remediate Soil and Water Pollution. In Advances in Applied Microbiology; Elsevier: Amsterdam, The Netherlands, 2004; Volume 56, pp. 313–330. ISBN 978-0-12-002658-6. [Google Scholar]
- Contreras-Cornejo, H.A.; Macías-Rodríguez, L.; Cortés-Penagos, C.; López-Bucio, J. Trichoderma Virens, a Plant Beneficial Fungus, Enhances Biomass Production and Promotes Lateral Root Growth through an Auxin-Dependent Mechanism in Arabidopsis. Plant Physiol. 2009, 149, 1579–1592. [Google Scholar] [CrossRef]
- Yadav, L.S.; Kushwaha, V.; Jain, A. Isolation and Screening of Phosphate Solubilizing Fungi from Okra Rhizosphere Soil and Their Effect on the Growth of Okra Plant (Abelmoschous esculentus L.). Trop. Plant Res. 2020, 7, 277–284. [Google Scholar] [CrossRef]
- Udoh, I.P.; Eleazar, C.I.; Ogeneh, B.O.; Ohanu, M.E. Studies on Fungi Responsible for the Spoilage/Deterioration of Some Edible Fruits and Vegetables. AiM 2015, 05, 285–290. [Google Scholar] [CrossRef]
- Alwakeel, S.S. Molecular Identification of Isolated Fungi from Stored Apples in Riyadh, Saudi Arabia. Saudi J. Biol. Sci. 2013, 20, 311–317. [Google Scholar] [CrossRef] [PubMed]
- Xu, F.; Cai, T.; Yang, X.; Sui, W. Soil Fungal Community Variation by Large-Scale Reclamation in Sanjiang Plain, China. Ann. Microbiol. 2017, 67, 679–689. [Google Scholar] [CrossRef]
- Li, H.; Liu, W.; Wan, F.; Cao, Y. Invasive Impacts of Ageratina adenophora (Asteraceae) on the Changes of Microbial Community Structure, Enzyme Activity and Fertility in Soil Ecosystem. Sci. Agric. Sin. 2009, 42, 3964–3971. [Google Scholar]
- Birkhofer, K.; Schöning, I.; Alt, F.; Herold, N.; Klarner, B.; Maraun, M.; Marhan, S.; Oelmann, Y.; Wubet, T.; Yurkov, A.; et al. General Relationships between Abiotic Soil Properties and Soil Biota across Spatial Scales and Different Land-Use Types. PLoS ONE 2012, 7, e43292. [Google Scholar] [CrossRef]
- Ye, X.; Huang, Z.-G.; Wu, H.-T. Carbon and Nitrogen Distributions and Microbial Characteristics in the Soils of Four Types of Wetlands in Sanjiang Plain, Northeast China. Yingyong Shengtai Xuebao 2014, 25, 2847–2854. [Google Scholar]
- Gyaneshwar, P.; Naresh Kumar, G.; Parekh, L.J.; Poole, P.S. Role of soil microorganisms in improving P nutrition of plants. Plant Soil 2002, 245, 83–93. [Google Scholar] [CrossRef]
- Zapata, F.; Zaharah, A.R. Phosphorus Availability from Phosphate Rock and Sewage Sludge as Influenced by the Addition of Water Soluble Phosphate Fertilizer. Nutr. Cycl. Agroecosyst. 2002, 63, 43–48. [Google Scholar] [CrossRef]
- Ali, S.; Khan, S.A.; Hamayun, M.; Iqbal, A.; Khan, A.L.; Hussain, A.; Shah, M. Endophytic Fungi from Caralluma acutangula Can Secrete Plant Growth Promoting Enzymes. Fresenius Environ. Bull. 2019, 28, 2688–2696. [Google Scholar]
- Khan, A.L.; Al-Harrasi, A.; Al-Rawahi, A.; Al-Farsi, Z.; Al-Mamari, A.; Waqas, M.; Asaf, S.; Elyassi, A.; Mabood, F.; Shin, J.-H.; et al. Endophytic Fungi from Frankincense Tree Improves Host Growth and Produces Extracellular Enzymes and Indole Acetic Acid. PLoS ONE 2016, 11, e0158207. [Google Scholar] [CrossRef]
- Nath, R.; Sharma, G.; Barooah, M. Plant Growth Promoting Endophytic Fungi Isolated from Tea (Camellia sinensis) Shrubs of Assam, India. Appl. Ecol. Environ. Res. 2015, 13, 877–891. [Google Scholar]
- Ripa, F.A.; Cao, W.; Tong, S.; Sun, J. Assessment of Plant Growth Promoting and Abiotic Stress Tolerance Properties of Wheat Endophytic Fungi. BioMed Res. Int. 2019, 2019, 6105865. [Google Scholar] [CrossRef] [PubMed]
- Mehmood, A.; Irshad, M.; Husna, A.A.; Hussain, A. In Vitro Maize Growth Promotion by Endophytic Fusarium Oxysporum WLW. J. Appl. Environ. Biol. Sci. 2018, 8, 30–35. [Google Scholar]
- Mehmood, A.; Khan, N.; Irshad, M.; Hamayun, M.; Husna, I.; Javed, A.; Hussain, A. IAA Producing Endopytic Fungus Fusariun Oxysporum Wlw Colonize Maize Roots and Promoted Maize Growth Under Hydroponic Condition. Eur. J. Exp. Biol. 2018, 8, 24. [Google Scholar] [CrossRef]
- Yoo, S.-J.; Shin, D.J.; Won, H.Y.; Song, J.; Sang, M.K. Aspergillus Terreus JF27 Promotes the Growth of Tomato Plants and Induces Resistance against Pseudomonas Syringae Pv. Tomato. Mycobiology 2018, 46, 147–153. [Google Scholar] [CrossRef] [PubMed]
- Wardeh, M.; Risley, C.; McIntyre, M.K.; Setzkorn, C.; Baylis, M. Database of Host-Pathogen and Related Species Interactions, and Their Global Distribution. Sci. Data 2015, 2, 150049. [Google Scholar] [CrossRef]

| Reclaimed Lands | Plantation | Sample Area | Code | Composite Samples | Replicates |
|---|---|---|---|---|---|
| Citrus Orchard (A) | Citrus trees 1 | Rhizosphere (R) | AR1 | 5 | 2x |
| Uncultivated (U) | AU1 | 5 | 2x | ||
| Citrus trees 2 | Rhizosphere (R) | AR2 | 5 | 2x | |
| Uncultivated (U) | AU2 | 5 | 2x | ||
| Olive Orchard (B) | Olives trees 1 | Rhizosphere (R) | BR1 | 5 | 2x |
| Uncultivated (U) | BU1 | 5 | 2x | ||
| Olives trees 2 | Rhizosphere (R) | BR2 | 5 | 2x | |
| Uncultivated (U) | BU2 | 5 | 2x | ||
| Desert Lands (D) | No plantations | Rhizosphere (R) | DU1 | 5 | 2x |
| DU2 | 5 | 2x | |||
| DU3 | 5 | 2x |
| Soil Samples Code | Vegetation | Sample Area | Total CFU/g |
|---|---|---|---|
| AR1 | Citrus trees | Rhizosphere | 3.8 × 103 |
| AU1 | Uncultivated | 1.6 × 103 | |
| AR2 | Citrus trees | Rhizosphere | 4.4 × 103 |
| AU2 | Uncultivated | 1.8 × 103 | |
| BR1 | Olives trees | Rhizosphere | 4.8 × 103 |
| BU1 | Uncultivated | 2.7 × 103 | |
| BR2 | Olives trees | Rhizosphere | 3.0 × 103 |
| BU2 | Uncultivated | 2.2 × 103 | |
| DU1 | Desert | Uncultivated | 1.2 × 102 |
| DU2 | 1.1 × 102 | ||
| DU3 | 0.7 × 102 |
| Species Code | Species Name | Reclaimed Land | Desert Land | |||
|---|---|---|---|---|---|---|
| Olives Trees | Citrus Trees | |||||
| R% | U% | R% | U% | |||
| SFSA1 | Aspergillus tubingensis | 7.69 | 4.08 | - | - | - |
| SFSA2 | Aspergillus flavus | 8.97 | - | - | - | 6.89 |
| SFSA3 | Aspergillus aculeatus | 6.41 | 6.12 | 8.53 | - | 6.89 |
| SFSA4 | Aspergillus niger | 2.56 | 6.12 | 6.09 | 8.82 | - |
| SFSA5 | Aspergillus ochraceus | - | - | - | - | 13.79 |
| SFSA6 | Aspergillus chevalieri | - | - | - | - | 10.34 |
| SFSA7 | Aspergillus fumigatus | - | - | 8.53 | - | 6.89 |
| SFSA8 | Aspergillus terreus | 7.69 | - | - | - | - |
| SFSA9 | Aspergillus sp. | 3.84 | 4.08 | 4.87 | 23.52 | - |
| SFSA10 | Penicillium oxalicum | 10.25 | 8.16 | 7.31 | 5.88 | - |
| SFSA11 | Penicillium digitatum | - | - | 6.09 | 8.82 | 6.89 |
| SFSA12 | Penicillium citrinum | 3.84 | 10.20 | 7.31 | 11.76 | - |
| SFSA13 | Epicoccum nigrum | 5.12 | 6.12 | - | - | - |
| SFSA14 | Fusarium oxysporum | 6.41 | 14.28 | 4.87 | 8.82 | 6.89 |
| SFSA15 | Fusarium acuminatum | - | - | 6.09 | 8.82 | - |
| SFSA16 | Fusarium brachygibbosum | - | - | 4.87 | - | - |
| SFSA17 | Fusarium solani | - | - | 7.31 | 2.94 | - |
| SFSA18 | Fusarium equiseti | 2.56 | 8.16 | - | - | - |
| SFSA19 | Ulocladium atrum | 2.56 | - | 8.82 | - | |
| SFSA20 | Ulocladium sp. | - | - | - | - | 13.79 |
| SFSA21 | Trichoderma harzianum | 11.53 | 14.28 | 6.09 | - | - |
| SFSA22 | Trichoderma stromaticum | 8.97 | 6.12 | 4.87 | 5.88 | - |
| SFSA23 | Trichoderma sp. | 3.84 | 4.08 | 4.87 | - | - |
| SFSA24 | Cladosporium herbarum | - | - | - | - | 10.34 |
| SFSA25 | Cladosporium oxysporum | - | - | 7.31 | 5.88 | - |
| SFSA26 | Cladosporium velox | - | - | - | - | 6.89 |
| SFSA27 | Chaetomium globosum | 7.69 | 6.12 | 4.87 | - | 10.34 |
| Fungal Species * | IAA Concentrations (µg/mL) * | |||||||||||
|---|---|---|---|---|---|---|---|---|---|---|---|---|
| pH5 NS | pH7 NS | pH9 NS | ||||||||||
| 0.1% b | 0.5% b | 1.0% a | 1.5% a | 0.1% b | 0.5% b | 1.0% a | 1.5% a | 0.1% b | 0.5% b | 1.0% a | 1.5% a | |
| A. tubingensis a | 27 | 75 | 240 | 176 | 10 | 126 | 215 | 260 | 63 | 25 | 73 | 84 |
| A. flavus a | 45 | 31 | 33 | 85 | 52 | 92 | 198 | 210 | 98 | 84 | 92 | 72 |
| A. niger ab | 76 | 75 | 72 | 89 | 95 | 87 | 124 | 85 | 59 | 79 | 75 | 73 |
| A. fumigatus a | 41 | 78 | 210 | 97 | 37 | 85 | 197 | 212 | 88 | 43 | 76 | 79 |
| A. terreus c | 16 | 22 | 35 | 83 | 43 | 7 | 36 | 39 | 35 | 56 | 79 | 85 |
| P. oxalicum c | 13 | 22 | 34 | 62 | 11 | 19 | 23 | 40 | 35 | 45 | 76 | 82 |
| P. citrinum c | 7 | 21 | 32 | 79 | 6 | 26 | 45 | 66 | 35 | 67 | 77 | 80 |
| F. oxysporum c | 22 | 31 | 34 | 75 | 23 | 19 | 40 | 33 | 35 | 53 | 57 | 61 |
| T. harzianum bc | 45 | 54 | 43 | 89 | 18 | 30 | 48 | 55 | 39 | 73 | 78 | 92 |
| C. globosum c | 32 | 31 | 34 | 22 | 19 | 43 | 79 | 50 | 62 | 76 | 63 | 78 |
Disclaimer/Publisher’s Note: The statements, opinions and data contained in all publications are solely those of the individual author(s) and contributor(s) and not of MDPI and/or the editor(s). MDPI and/or the editor(s) disclaim responsibility for any injury to people or property resulting from any ideas, methods, instructions or products referred to in the content. |
© 2023 by the authors. Licensee MDPI, Basel, Switzerland. This article is an open access article distributed under the terms and conditions of the Creative Commons Attribution (CC BY) license (https://creativecommons.org/licenses/by/4.0/).
Share and Cite
Nafaa, M.; Rizk, S.M.; Aly, T.A.-G.A.; Rashed, M.A.-S.; Abd El-Moneim, D.; Ben Bacha, A.; Alonazi, M.; Magdy, M. Screening and Identification of the Rhizosphere Fungal Communities Associated with Land Reclamation in Egypt. Agriculture 2023, 13, 215. https://doi.org/10.3390/agriculture13010215
Nafaa M, Rizk SM, Aly TA-GA, Rashed MA-S, Abd El-Moneim D, Ben Bacha A, Alonazi M, Magdy M. Screening and Identification of the Rhizosphere Fungal Communities Associated with Land Reclamation in Egypt. Agriculture. 2023; 13(1):215. https://doi.org/10.3390/agriculture13010215
Chicago/Turabian StyleNafaa, Mostafa, Samah Mohamed Rizk, Tahany Abdel-Ghafar Ahmed Aly, Mohamed Abdel-Salam Rashed, Diaa Abd El-Moneim, Abir Ben Bacha, Mona Alonazi, and Mahmoud Magdy. 2023. "Screening and Identification of the Rhizosphere Fungal Communities Associated with Land Reclamation in Egypt" Agriculture 13, no. 1: 215. https://doi.org/10.3390/agriculture13010215
APA StyleNafaa, M., Rizk, S. M., Aly, T. A.-G. A., Rashed, M. A.-S., Abd El-Moneim, D., Ben Bacha, A., Alonazi, M., & Magdy, M. (2023). Screening and Identification of the Rhizosphere Fungal Communities Associated with Land Reclamation in Egypt. Agriculture, 13(1), 215. https://doi.org/10.3390/agriculture13010215

